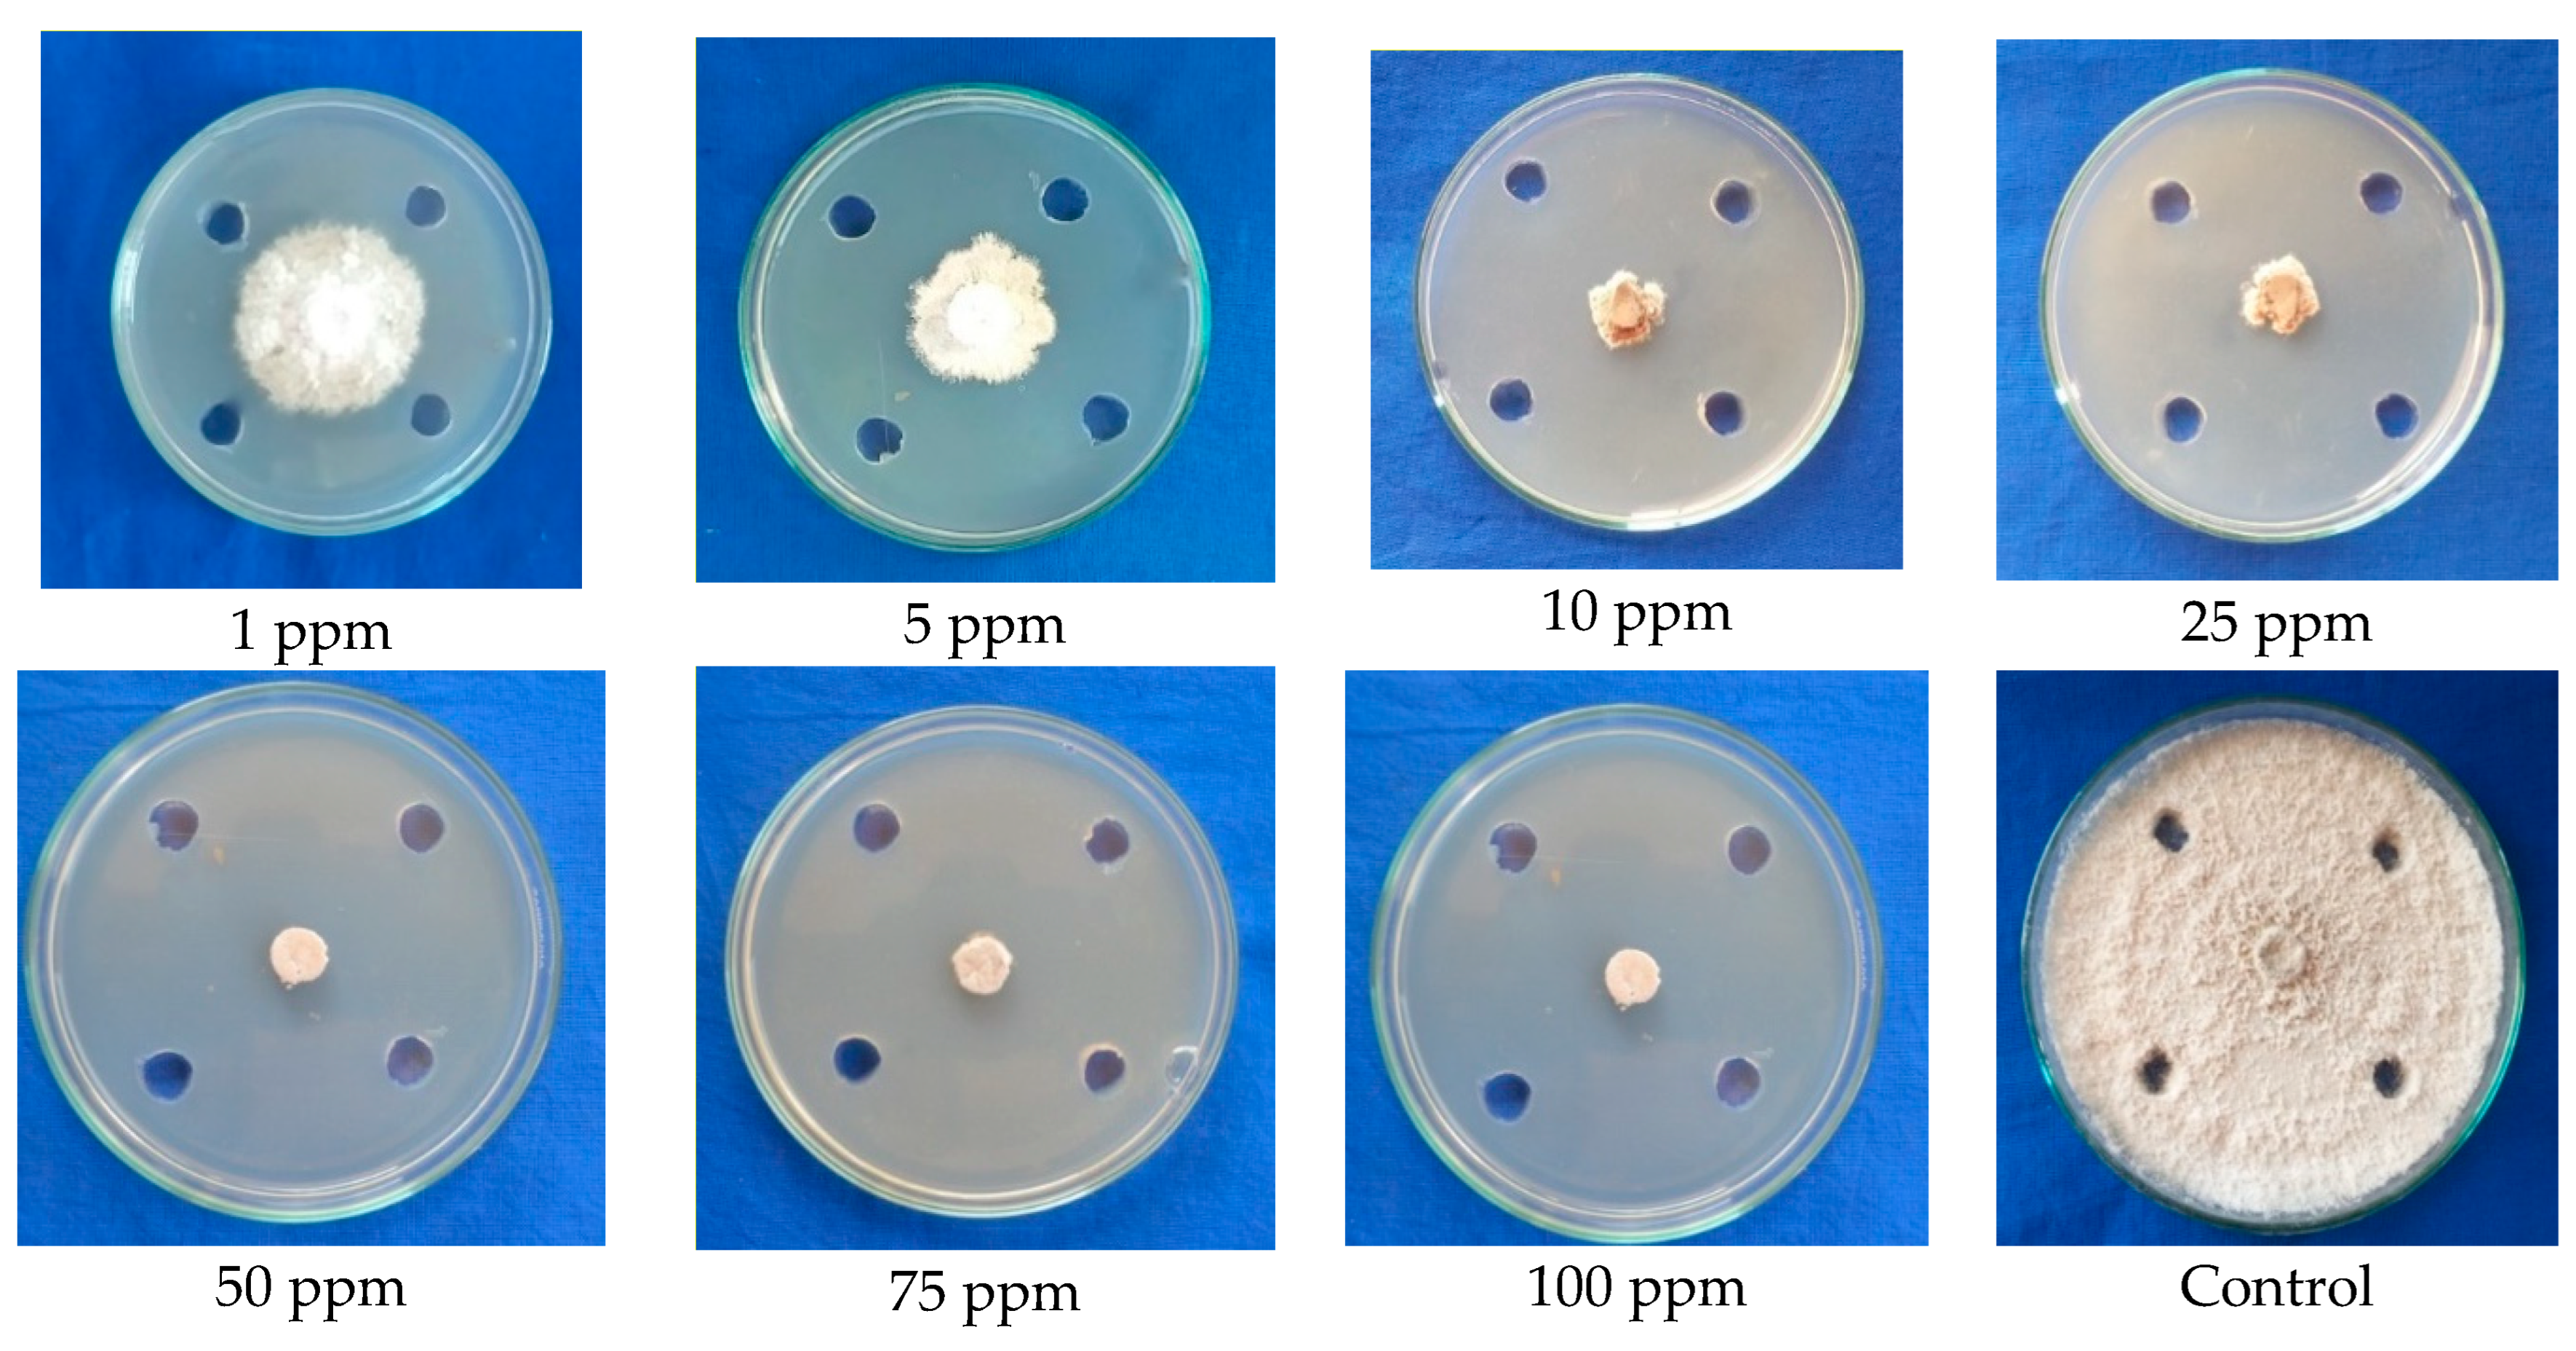
Molecules 28 02476 g005 Molecules 28 02476 g005
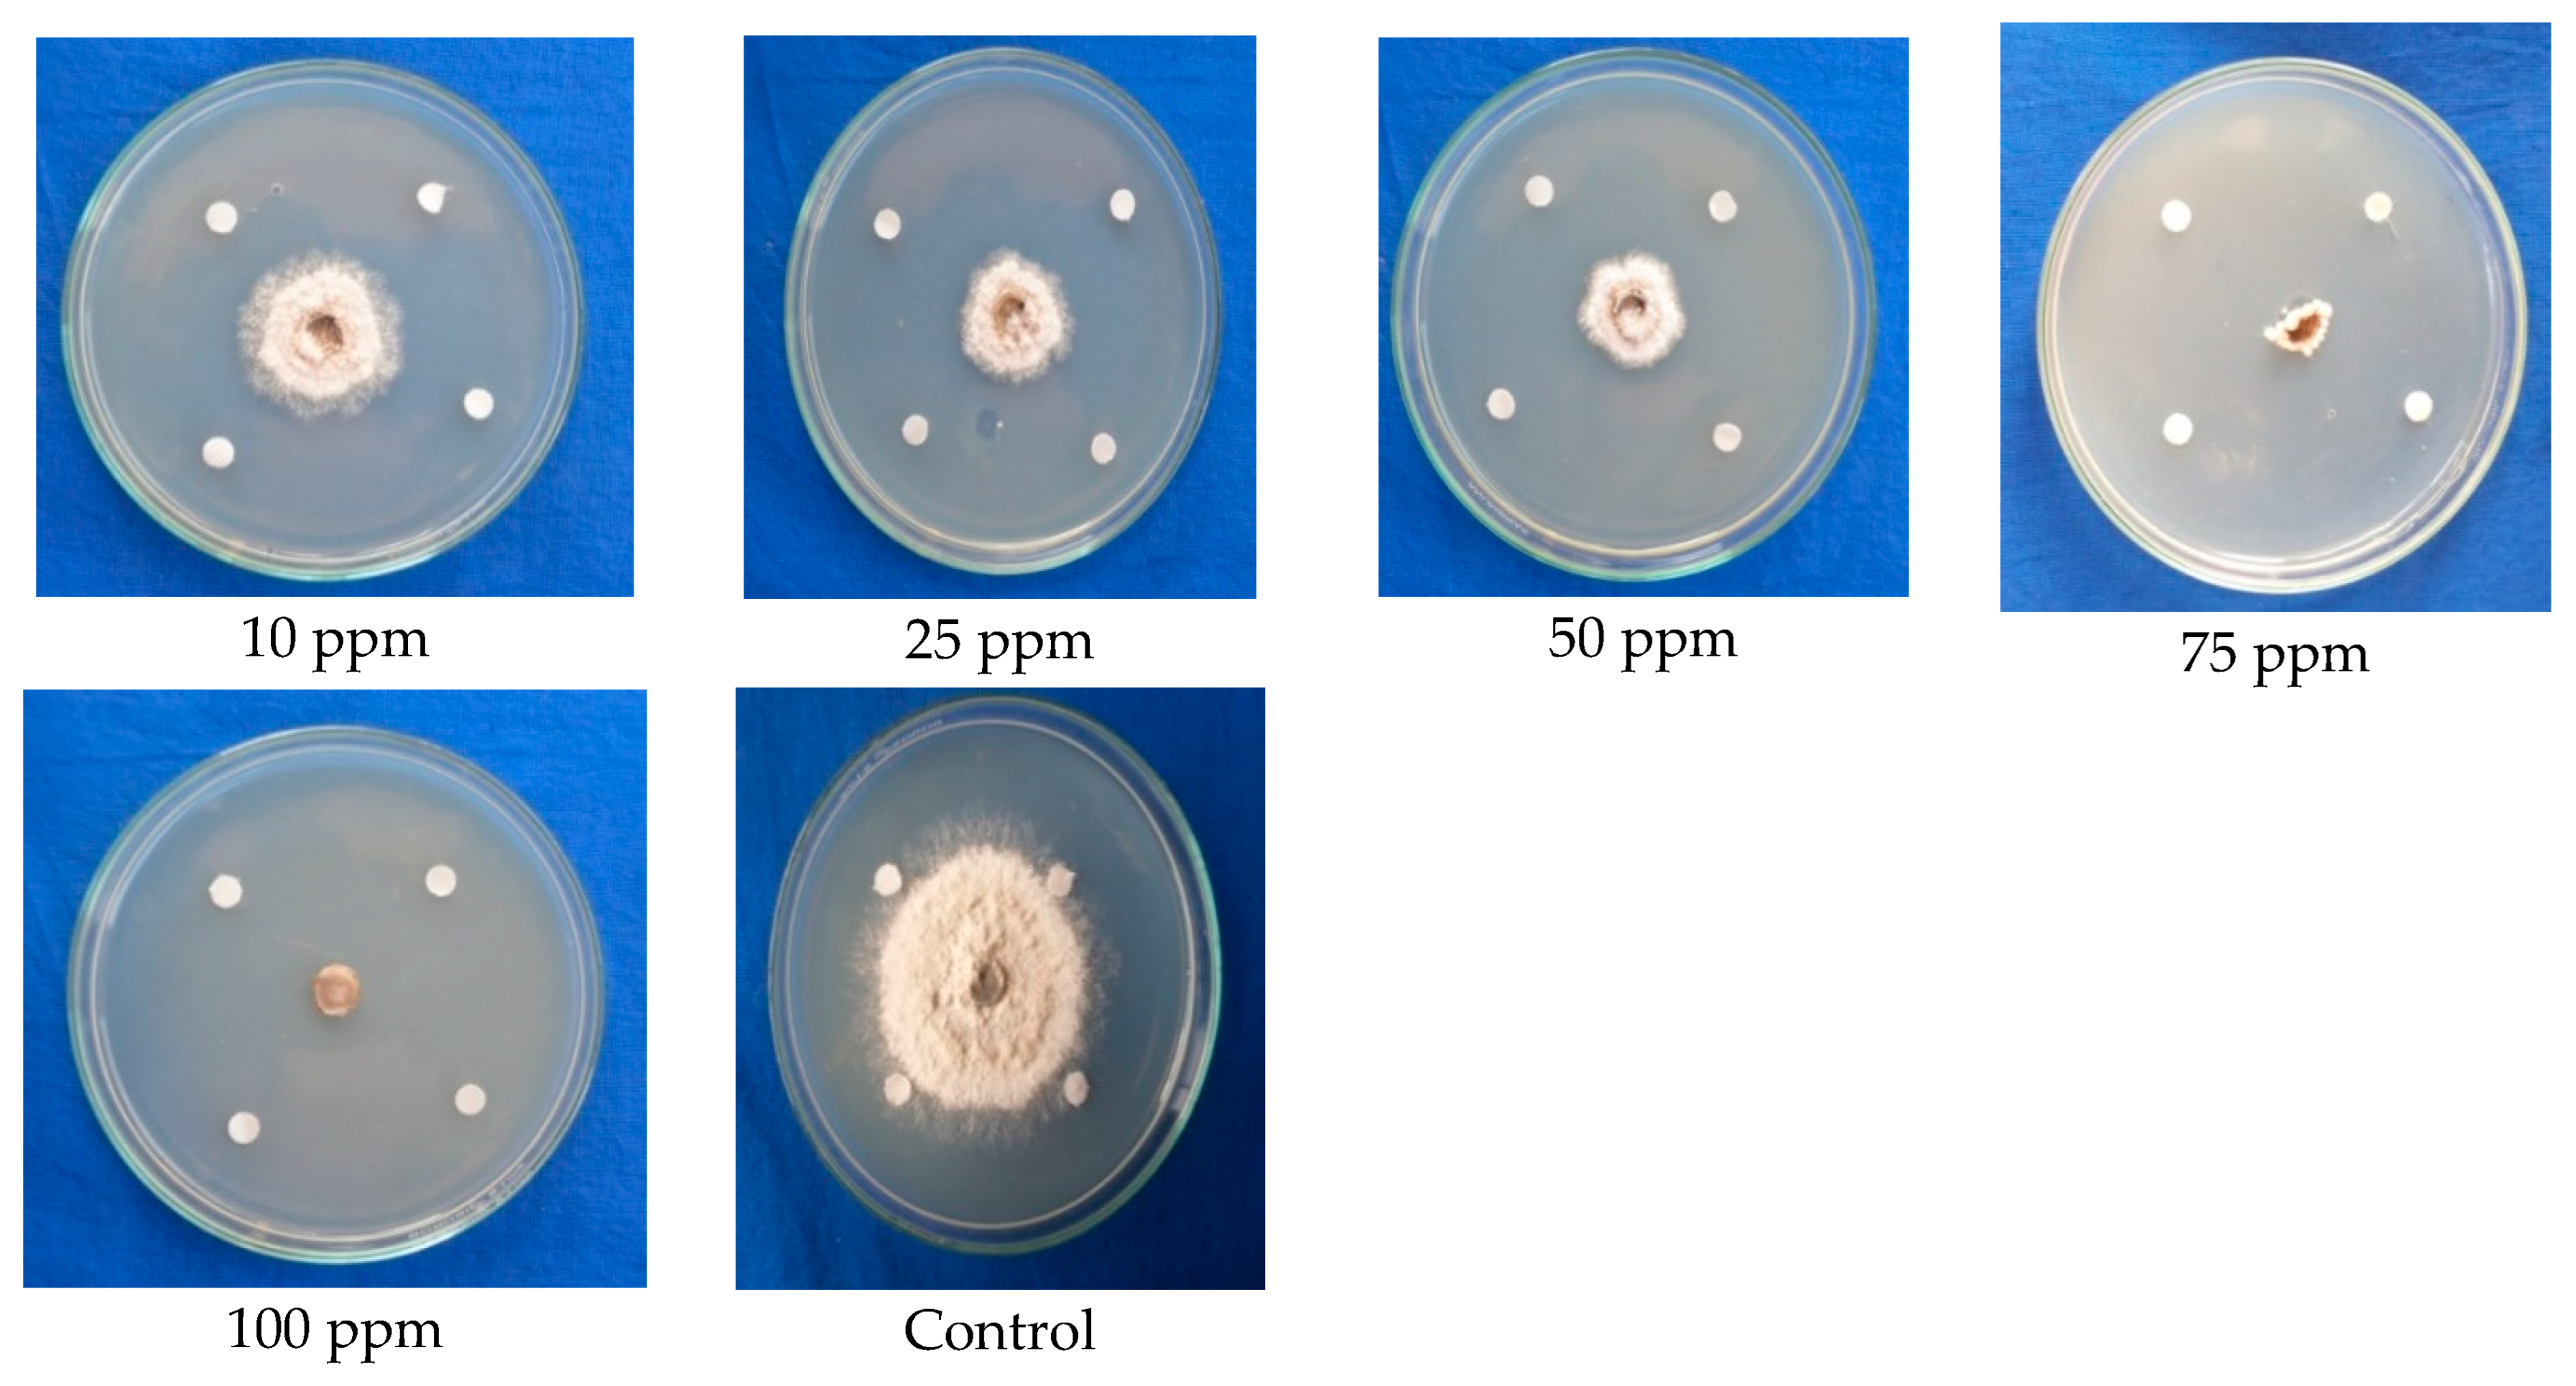
Molecules 28 02476 g006 Molecules 28 02476 g006

Benzothiazole—An Antifungal Compound Derived from Medicinal Mushroom Ganoderma lucidum against Mango Anthracnose Pathogen Colletotrichum gloeosporioides (Penz and (Sacc.))
Abstract
1. Introduction
2. Results
2.1. Testing the Ethyl Acetate Extracted Antimicrobial Compound from Fruiting Body (Cap and Stipe) of G. lucidum against the C. gloeosporioides
2.2. Identifying the Presence of Antifungal Biomolecules from Ethyl Acetate Solvent Extracts of Fruiting Body (Cap) of G. lucidum through TLC Studies
2.3. Detection of Antimicrobial Compound from Cap Portion of Fruiting Body of G. lucidum through GC-MS
2.4. Testing the Antifungal Activity of Standard Sample of Benzothiazole against C. gloeosporioides
2.4.1. Testing Antifungal Activity of Benzothiazole (Standard Sample) at Different Concentrations against Mycelial Growth of C. gloeosporioides (Agar Well Diffusion)
2.4.2. Confirming the Antifungal Activity of Benzothiazole (Standard Sample) against Mycelial Growth of C. gloeosporioides (Paper Disc Assay)
2.4.3. Testing the Effect of Benzothiazole (Standard Sample) at Optimum Concentration (50 ppm) on Conidial Germination of C. gloeosporioides
2.5. Antifungal Effect of Benzothiazole (Standard Sample) against Spores and Mycelium of C. gloeosporioides by Scanning Electron Microscopy (SEM)
3. Discussion
4. Material and Methods
4.1. Production of the Fruiting Body of G. lucidum
4.2. Extraction of Antimicrobial Compounds from Fruiting Body of G. lucidum
In Vitro Antimicrobial Activity of Ethyl Acetate Extracts from Fruiting Body of G. lucidum against C. gloeosporioides
4.3. Identification of Antimicrobial Compounds Solvent Extracts of the Fruiting Body (Cap) of G. lucidum through TLC
Testing the Antifungal Activity of TLC Eluted Compounds of G. lucidum against C. gloeosporioides
4.4. Profiling of Antimicrobial Compounds from G. lucidum through GC-MS
4.5. Testing the Antifungal Activity of the Standard Sample (Benzothiazole) against C. gloeosporioides
4.6. Effect of Standard Sample Benzothiazole on C. gloeosporioides under Scanning Electron Microscopy
4.7. Statistical Analysis
5. Conclusions
Supplementary Materials
Author Contributions
Funding
Institutional Review Board Statement
Informed Consent Statement
Data Availability Statement
Acknowledgments
Conflicts of Interest
Sample Availability
References
- Leharwan, S.; Malik, V.K.; Rajender, S.; Leharwan, M. Effect of Culture Media and Temperature on Growth and Sporulation Colletotrichum gloeosporioides cause of Anthracnose Disease of Mango. Int. J. Curr. Microbiol. Appl. Sci. 2018, 7, 1835–1842. [Google Scholar] [CrossRef]
- Arauz, L.F. Mango anthracnose: Economic impact and current options for integrated management. Plant Dis. 2000, 84, 600–611. [Google Scholar] [CrossRef] [PubMed]
- Jha, S.N.; Narsaiah, K.; Sharma, A.D.; Singh, M.; Bansal, S.; Kumar, R. Quality parameters of mango and potential of non-destructive techniques for their measurement—A review. J. Food Sci. Technol. 2010, 47, 1–14. [Google Scholar] [CrossRef] [PubMed]
- Poucheret, P.; Françoise, F.; Sylvie, R. Biological and pharmacological activity of higher fungi: 20-year retrospective analysis. Cryptogam. Mycol. 2006, 27, 311. [Google Scholar]
- Zahid, S.; Chibuike, C.U.; Athar, A.; Michael, O.E.; Edward, P.S.; Paul, H. New bioactive natural products from Coprinus Micaceus. Nat. Prod. Res. 2006, 20, 1283–1289. [Google Scholar] [CrossRef] [PubMed]
- Imtiaj, A.; Lee, T.S. Screening of antibacterial and antifungal activities from Korean wild mushrooms. World J. Agric. Sci. 2007, 3, 316–321. [Google Scholar]
- Jonathan, S.G.; Awotona, F. Studies on antimicrobial potentials of three Ganoderma species. Afr. J. Biomed. Res. 2010, 13, 131–139. [Google Scholar]
- Ganesh, K. Exploration of Antifungal Bioactive Compounds of Pisolithus tinctorius (Pers) Coker against Some Soil Borne Plant Pathogens. Ph.D. Thesis, Tamil Nadu Agric University, Coimbatore, India, 2014. [Google Scholar]
- Priya, K.; Thiribhuvanamala, G.; Kamalakannan, A.; Krishnamoorthy, A.S. Antimicrobial Activity of Biomolecules from Mushroom Fungi against Colletotrichum capsici (Syd.) Butler and Bisby, the Fruit Rot Pathogen of Chilli. Int. J. Curr. Microbiol. A Sci. 2019, 8, 1172–1186. [Google Scholar] [CrossRef]
- Jeeva, S.; Krishnamoorthy, A.S. Antifungal Potential of Myco-molecules of Coprinopsis cinerea (Schaeff) S. Gray s. lat. against Fusarium spp. Madras Agric. J. 2018, 105, 1. [Google Scholar]
- Priya, K. Characterization of antimicrobial compounds from mushroom fungi and medicinal plants against Colletotrichum capsici (syd.) Butler and Bisby, an inciting agent of chilli anthracnose. Master’s Thesis, Tamil Nadu Agric University, Coimbatore, India, 2019; pp. 36–46. [Google Scholar]
- Lindequist, U.; Niedermeyer, T.H.; Jülich, W.-D. The pharmacological potential of mushrooms. Evid. -Based Complement. Altern. Med. 2005, 2, 289–299. [Google Scholar] [CrossRef] [PubMed]
- Kanokmedhakul, S.; Kwanjai, K.; Thirada, P.; Kasem, S.; Palangpon, K.; Apichart, S. A bioactive triterpenoid and vulpinic acid derivatives from the mushroom Scleroderma citrinum. Planta Med. 2003, 69, 568–571. [Google Scholar] [PubMed]
- Soytong, K.; Phoutthasone, S.; Kwanchai, K.; Somdej, K. Biological active compounds of Scleroderma citrinum that inhibit plant pathogenic fungi. J. Agric. Technol. 2014, 10, 79–86. [Google Scholar]
- Mei, X.; Liu, Y.; Huang, H.; Du, F.; Huang, L.; Wu, J.; Li, Y.; Zhu, S.; Yang, M. Benzothiazole inhibits the growth of Phytophthora capsici through inducing apoptosis and suppressing stress responses and metabolic detoxification. Pestic. Biochem. Physiol. 2019, 154, 7–16. [Google Scholar] [CrossRef] [PubMed]
- Thangaraj, P.; Balamurali, A.S.; Subbiah, K.A.; Sevugapperumal, N.; Gurudevan, T.; Uthandi, S.; Shanmugam, H. Antifungal Volatilomes Mediated Defense Mechanism against Fusarium oxysporum f. sp. lycopersici, the Incitant of Tomato Wilt. Molecules 2022, 27, 3631. [Google Scholar] [PubMed]

| Concentration (%) | Solvent Extracts of G. lucidum- Cap | Solvent Extracts of G. lucidum- Stipe | ||
|---|---|---|---|---|
| * Mean Mycelial Growth (mm) | Percent Inhibition over Control | * Mean Mycelial Growth (mm) | Percent Inhibition over Control | |
| 0.05 | 52.1 (46.15) | 42.20 e (40.51) | 90.0 (71.61) | 0.00 |
| 0.1 | 48.3 (44.00) | 46.60 d (43.05) | 90.0 (71.61) | 0.00 |
| 0.2 | 41.6 (40.14) | 53.77 c (47.16) | 58.6 (49.93) | 34.00 d (35.65) |
| 0.4 | 40.2 (39.33) | 55.59 c (48.26) | 57.6 (49.35) | 36.10 bc (36.91) |
| 0.6 | 36.0 (36.85) | 60.00 b (50.77) | 58.3 (49.75) | 35.22 cd (36.38) |
| 0.8 | 30.0 (33.19) | 67.71 a (55.38) | 56.3 (48.60) | 37.44 b (37.71) |
| 1.0 | 26.7 (31.09) | 70.10 a (56.85) | 53.3 (46.87) | 40.77 a (39.66) |
| Control | 90.0 (70.61) | 0.0 (0.51) | 90.0 (71.61) | 0.00 (0.57) |
| SE(d) | 0.515 | - | 1.155 | - |
| CD (p = 0.05) | 1.114 | - | 2.502 | - |
| Compound | * Mean Mycelial Growth (mm) | Percent Inhibition over Control |
|---|---|---|
| Band 1 | 48.3 (44.00) | 46.33 b (42.87) |
| Band 2 | 41.6 (40.14) | 53.77 a (47.16) |
| Control | 90.0 (71.61) | 0.0 (0.57) |
| SE (d) | 0.562 | - |
| CD (p = 0.05) | 1.603 | - |
| RT | Compound | Biological Activity | Molecular Weight (g/mol) | Molecular Formula |
|---|---|---|---|---|
| 14.16 | 5H-Cyclopropa[3,4]benz[1,2-e]azulen-5-one | Antibacterial anti inflammatory | 506.548 | C26H34O10 |
| 15.10 | Diisooctyl phthalate | - | 390.564 | C24H38O4 |
| 17.71 | Docosanoic acid, 1,2,3-propanetriyl | Emulsifying agent | 1059.825 | C69H134O6 |
| 18.42 | Propanoic acid | Antifungal | 74.079 | C3H6O2 |
| 22.03 | Benzothiazole | Antifungal | 135.19 | C7H5NS |
| 26.29 | 7,8-Epoxylanostan-11-ol,3-acetoxy- | Antimicrobial | 502.78 | C32H54O4 |
| Conc. (ppm) | * Mean Mycelial Growth (mm) | Percent Inhibition over Control | Growth Pattern of Mycelium |
|---|---|---|---|
| 1 | 40.10 | 55.44 c | Mycelium pushed back near the agar well zone |
| (39.27) | (48.10) | ||
| 5 | 35.30 | 60.77 c | Distortion in growth pattern of mycelium |
| (36.43) | (51.20) | ||
| 10 | 6.00 | 93.33 b | Blackening of mycelial growth |
| (14.17) | (75.29) | ||
| 25 | 4.20 | 95.53 b | Distortion of mycelial growth |
| (11.82) | (78.06) | ||
| 50 | 0.00 | 100.00 a | Breakage in the mycelial disc |
| (0.51) | (80.38) | ||
| 75 | 0.00 | 100.00 a | Completely arrested mycelium |
| (0.51) | (80.38) | ||
| 100 | 0.00 | 100.00 a | Completely arrested mycelium |
| (0.51) | (80.38) | ||
| Control | 90.0 | 0.00 | Normal growth of mycelium with concentric rings |
| (71.61) | (0.57) | ||
| SE (d) | 0.353 | - | - |
| CD (p = 0.05) | 0.827 | - | - |
| Minimum Fungicidal Concentration (ppm) | * Mean Mycelial Growth (mm) | Percent Inhibition over Control | Growth Pattern |
|---|---|---|---|
| 10 | 37.1 | 58.77 b | Linear mycelium growth towards the paper disc |
| (37.50) | (50.54) | ||
| 25 | 35.3 | 60.77 b | Changes in growth pattern of the mycelium |
| (36.43) | (51.22) | ||
| 50 | 32.1 | 64.44 b | Retardation of mycelium from the paper disc |
| (34.46) | (53.39) | ||
| 75 | 0.00 | 100.00 a | Shrinkage of mycelial disc |
| (0.57) | (84.16) | ||
| 100 | 0.00 | 100.00 a | No growth of mycelium |
| (0.57) | (84.16) | ||
| Control | 70.4 | 0.00 | Normal growth of mycelium with concentric rings |
| (56.85) | (0.57) | ||
| SE (d) | 0.453 | - | |
| CD (p = 0.05) | 1.130 | - |
| Time of Interval | Conidial Germination of C. gloeosporioides at 50 ppm | Reduction in Germination Percent over Control | |
|---|---|---|---|
| Control (No.) | Treatment (No.) | ||
| 6 h | 0.00 | 0.00 | 0.00 |
| 12 h | 26.82 (31.191) | 0.00 | 100 |
| 24 h | 50.34 (45.19) | 0.00 | 100 |
| CD (p = 0.05) | 1.649 | ||
Disclaimer/Publisher’s Note: The statements, opinions and data contained in all publications are solely those of the individual author(s) and contributor(s) and not of MDPI and/or the editor(s). MDPI and/or the editor(s) disclaim responsibility for any injury to people or property resulting from any ideas, methods, instructions or products referred to in the content. |
© 2023 by the authors. Licensee MDPI, Basel, Switzerland. This article is an open access article distributed under the terms and conditions of the Creative Commons Attribution (CC BY) license (https://creativecommons.org/licenses/by/4.0/).
Share and Cite
Muniyappan, G.; Gurudevan, T.; Thangaraj, P.; Balamurali, A.S.; Iyadurai, A.P.; Suppaiah, R.; Subbiah, K.A.; Shanmugam, H. Benzothiazole—An Antifungal Compound Derived from Medicinal Mushroom Ganoderma lucidum against Mango Anthracnose Pathogen Colletotrichum gloeosporioides (Penz and (Sacc.)). Molecules 2023, 28, 2476. https://doi.org/10.3390/molecules28062476
Muniyappan G, Gurudevan T, Thangaraj P, Balamurali AS, Iyadurai AP, Suppaiah R, Subbiah KA, Shanmugam H. Benzothiazole—An Antifungal Compound Derived from Medicinal Mushroom Ganoderma lucidum against Mango Anthracnose Pathogen Colletotrichum gloeosporioides (Penz and (Sacc.)). Molecules. 2023; 28(6):2476. https://doi.org/10.3390/molecules28062476
Chicago/Turabian StyleMuniyappan, Gayathri, Thiribhuvanamala Gurudevan, Praveen Thangaraj, Akshaya Subbaih Balamurali, Arumuka Pravin Iyadurai, Rajamanickam Suppaiah, Krishnamoorthy Akkanna Subbiah, and Haripriya Shanmugam. 2023. "Benzothiazole—An Antifungal Compound Derived from Medicinal Mushroom Ganoderma lucidum against Mango Anthracnose Pathogen Colletotrichum gloeosporioides (Penz and (Sacc.))" Molecules 28, no. 6: 2476. https://doi.org/10.3390/molecules28062476
APA StyleMuniyappan, G., Gurudevan, T., Thangaraj, P., Balamurali, A. S., Iyadurai, A. P., Suppaiah, R., Subbiah, K. A., & Shanmugam, H. (2023). Benzothiazole—An Antifungal Compound Derived from Medicinal Mushroom Ganoderma lucidum against Mango Anthracnose Pathogen Colletotrichum gloeosporioides (Penz and (Sacc.)). Molecules, 28(6), 2476. https://doi.org/10.3390/molecules28062476






